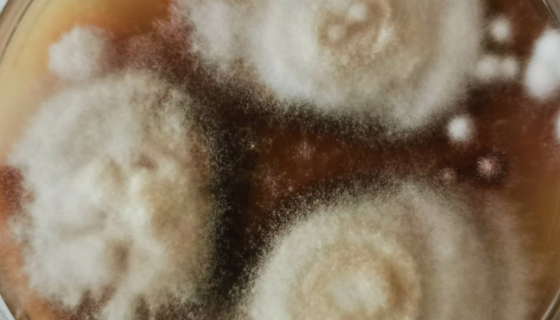
红色毛癣菌的生长速度与镜下形态及鉴别依据！

金黄色葡萄球菌的危害及感染的预防方法!
金黄色葡萄球菌是一种重要的人兽共患病原菌,隶属于葡萄球菌属,...

白色念珠菌病的临床症状及预防与治疗!
白色念珠菌(Monilia albican 或 candid...

L2大鼠肺泡上皮细胞的背景与应用!
L2大鼠肺泡上皮细胞(大鼠Ⅱ型肺泡上皮细胞)分离自肺组织;Ⅱ...
红色毛癣菌的生长速度与镜下形态及鉴别依据!
红色毛癣菌是毛癣菌属下的一个种。是一种人源的皮癣菌,引起常见...

毕赤酵母Gs115的菌株简介及注意事项有哪些?
毕赤酵母,甲醇营养型酵母中的一类能够利用甲醇作为碳源和能源的...

宇佐美曲霉的功效特征与生物现状及研究进展!
宇佐美曲霉(Aspergillus usamil),以野生植...

军团菌的病原特点与临床表现及诊断与治疗!
军团菌是胞内寄生菌,需氧G-棒状杆菌。适宜温度25~42℃,...

人子宫内膜上皮细胞永生化的使用方法与注意事项!
子宫是产生月经和孕育胎儿的器官,位于骨盆腔中央,在膀胱与直肠...

珊瑚色诺卡氏菌的菌株特征与培养条件及相关研究!
珊瑚色诺卡氏菌属于医药菌株,在营养琼脂上菌落圆形,边缘波状。...